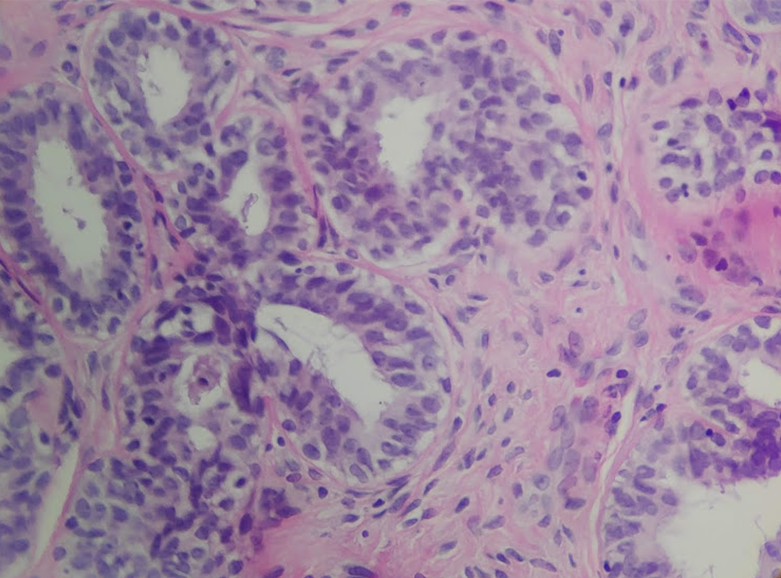
joemdoc's tweet image. Skene gland hyperplasia. Quite rare. 
#twitterPath #PathResidents #gynpath

#twitterpath search results
Just discovered that my mother thinks ‘Cytology’ is looking only at cytoplasm. My mom thinks I’ve been just looking at free floating cytoplasm for months now. #twitterpath #pathtwitter #pathology #cytology @UTMB_Pathology
.@nephjc RT @draalok: #renalpath #askrenal #TwitterPath #electronmicroscopy #ultrastructure @askrenal Subepithelial spherules: enigmatic…
Inflammatory fibroid polyp of the gastric antrum. An extremely rare entity that represents 0.1% of gastric polyps. This was localized in the gastric antrum of a 72 year old woman. #pathology #twitterpath




Hi #twitterpath family! Can you help my colleague @ARequesPath ? #gynpath @lara_pijuan @smlungpathguy @JMGardnerMD @kriyer68
26 year old male with fever and generalised weakness for 05 days presents with a total leukocyte count of 88,500. He is supposed to get married next week! #PathTwitter #twitterpath #pathresident #pathology #hematology #hematopat #hemepath #diagnosis #leukemia



Bladder mass , different biopsies in the background of bilharzial cystitis #pathology #GUpath #twitterpath




Cartilaginous lesion. Entrapment or encasement?🤔 #BSTPath #pathology #twitterpath #residentspath #digipath


Excited to be a part of CAP23 in Chicago! @Pathologists #Pathology #TwitterPath #LoveForPath #Path2Path #Network #Exhibits #Education
Particular strengths of the University of Utah Department of Pathology Residency Program includes a national reference laboratory owned by the University of Utah (ARUP Laboratories) says Dr. Smock @SmockKristi #PutPathOnTheMap #PathResidency #TwitterPath medicine.utah.edu/pathology/resi…

Older pt w/DN, MGUS. Worsening renal function + proteinuria. Bx: mildly active endocapillary proliferative GN + segmental fibrous crescents. IF: C3 only. k/L (-). EM with fusiform intramembranous deposits: Dense deposit disease (monoclonal Ig associated). #renalpath #twitterpath




When the mother takes the spotlight! @captmanoj #PathTwitter #twitterpath #pathology #pathresident #lymphnode

A keratin pearl of a Seb K being torn apart during processing. #pathology #twitterpath #dermpath #pathart


First case of 2023.🥳🥳 35 years female swelling over right maxillary region. 😯 What am I? 🤔 #TwitterPath #PathTwitter #OralPathology #MedTwitter

@JosAnto57447393 Demos la bienvenida al Dr Ruiz Macia. Welcome to Twitter José Antonio. Welcome to #TwitterFamily #twitterpath

#TwitterPath, I’m excited to announce my new Educational Project: @8bitPathology I’ll be posting cases, unknowns, and #pathtips; no/few retweets or dialogue. Why #8bitPath? Because I love #pathology, & I like old-school arcade #pixelart👾 Consider a follow! #ASCP40UnderForty

A keratin pearl of a Seb K being torn apart during processing. #pathology #twitterpath #dermpath #pathart


Bladder mass , different biopsies in the background of bilharzial cystitis #pathology #GUpath #twitterpath




Attention #ASCP2018 attendees! Meet up at @pathologistmag booth #102, Thursday at 12:30PM for a massive #twitterpath photo! #ascp2018 #pathpowerlist #Pathologists

40 yo female with vaginal hemorrhage and a protruding mass from the uterine cervix. #pathology #twitterpath



¿Recuerdas cuando te uniste a Twitter? ¡Yo sí! #MiAniversarioDeTwitter 3 años compartiendo con esta gran familia de patólogos del mundo #TwitterFamily #TwitterPath

Inflammatory fibroid polyp of the gastric antrum. An extremely rare entity that represents 0.1% of gastric polyps. This was localized in the gastric antrum of a 72 year old woman. #pathology #twitterpath




#renalpath #askrenal #TwitterPath #electronmicroscopy #ultrastructure @askrenal Subepithelial spherules: enigmatic structures resembling viral particles.. possibly derived from visceral epithelial cell cytoplasm. Any thoughts on origin & significance?




Something went wrong.
Something went wrong.
United States Trends
- 1. Air Canada N/A
- 2. Good Monday N/A
- 3. LaGuardia N/A
- 4. #MondayMotivation N/A
- 5. #DMDWORLDINTOKYO N/A
- 6. #YUNA_IceCream N/A
- 7. Port Authority N/A
- 8. O God N/A
- 9. Iowa N/A
- 10. Whale - Buy N/A
- 11. Runway 4 N/A
- 12. FDV 5min N/A
- 13. Lio Rush N/A
- 14. Theresa N/A
- 15. Simone N/A
- 16. Todd Golden N/A
- 17. TOP CALL N/A
- 18. Christopher Columbus N/A
- 19. QUICK TRADE N/A
- 20. Smart Money - Buy N/A